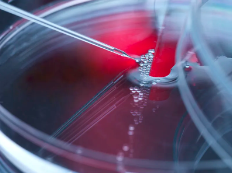
image.png

干細(xì)胞面部抗衰安不安全,有沒有效果
2024-11-18 16:09:22 來源: 小編 咨詢醫(yī)生
干細(xì)胞面部抗衰老技術(shù)作為一種前沿的抗衰老手段,近年來受到了廣泛關(guān)注。然而,許多人對其安全性和效果產(chǎn)生了疑問。下面,我們來詳細(xì)探討一下干細(xì)胞面部抗衰老的安全性和效果。
一、干細(xì)胞面部抗衰老的原理
干細(xì)胞是一種具有自我更新和分化能力的細(xì)胞,可以分化為各種類型的細(xì)胞。面部抗衰老的干細(xì)胞技術(shù)主要利用干細(xì)胞的分化能力,將干細(xì)胞注射到皮膚組織中,促進(jìn)皮膚細(xì)胞再生,從而達(dá)到改善皮膚質(zhì)地、消除皺紋、恢復(fù)年輕態(tài)的目的。
二、干細(xì)胞面部抗衰老的安全性
1.來源安全:面部抗衰老所用的干細(xì)胞主要來源于自體脂肪、骨髓、血液等,這些來源的干細(xì)胞在提取和培養(yǎng)過程中,不會產(chǎn)生免疫排斥反應(yīng),安全性較高。
2.操作安全:干細(xì)胞面部抗衰老技術(shù)的操作過程相對簡單,類似于注射美容。在正規(guī)醫(yī)療機構(gòu)進(jìn)行操作,遵循無菌原則,可以有效降低感染風(fēng)險。
3.副作用較?。焊杉?xì)胞面部抗衰老技術(shù)副作用相對較小,如紅腫、疼痛等,這些癥狀通常在短期內(nèi)可以自行消退。
三、干細(xì)胞面部抗衰老的效果
1.改善皮膚質(zhì)地:干細(xì)胞面部抗衰老技術(shù)可以促進(jìn)皮膚細(xì)胞再生,提高皮膚彈性,使皮膚更加緊致、光滑。
2.消除皺紋:干細(xì)胞注射到皮膚組織中,可以促進(jìn)皮膚組織修復(fù),消除皺紋,使面部輪廓更加年輕。
3.恢復(fù)年輕態(tài):干細(xì)胞面部抗衰老技術(shù)可以改善面部輪廓,恢復(fù)年輕態(tài),提升整體氣質(zhì)。
4.延緩衰老:干細(xì)胞面部抗衰老技術(shù)可以從根本上延緩皮膚衰老過程,使面部年輕化。
然而,需要注意的是,干細(xì)胞面部抗衰老技術(shù)的效果并非一蹴而就,需要一定的時間才能顯現(xiàn)。此外,每個人的個體差異較大,效果也會有所不同。在選擇該項技術(shù)時,求美者應(yīng)保持理性,選擇正規(guī)醫(yī)療機構(gòu)進(jìn)行咨詢和治療。
總之,干細(xì)胞面部抗衰老技術(shù)在安全性較高的情況下,具有一定的抗衰老效果。求美者在選擇該項技術(shù)時,應(yīng)充分了解相關(guān)信息,謹(jǐn)慎決策。
- 2024-10-28人體注射干細(xì)胞抗衰老效果好嗎?
- 2024-11-11干細(xì)胞移植抗衰老效果怎樣,需要什么流程
- 2024-11-23干細(xì)胞抗衰能堅持多久呢,長期效果如何評估
- 2024-07-31美容抗衰干細(xì)胞,干細(xì)胞美容功效與作用
- 2024-09-24干細(xì)胞抗衰老口服膠囊有用嗎,功效與作用詳解
- 2024-12-07干細(xì)胞治療早衰效果如何,選擇醫(yī)院需考慮哪些關(guān)鍵點
- 2024-09-11醫(yī)院干細(xì)胞存儲費用多少,2024最新細(xì)胞儲存方案
- 2024-07-21干細(xì)胞應(yīng)用,干細(xì)胞應(yīng)用的主要方向有哪些
- 2024-09-04溫州干細(xì)胞存儲的費用詳解
- 2024-09-28國家批準(zhǔn)的干細(xì)胞醫(yī)院有哪幾家,這十家醫(yī)院榜上有名
- 2024-09-16湖南生物干細(xì)胞存儲公司排名榜單公布
- 2024-09-09江西免疫干細(xì)胞功效,回輸有風(fēng)險嗎
- 2024-09-11植物干細(xì)胞激活技術(shù)原理詳解
- 2024-08-09廣州干細(xì)胞醫(yī)治偏癱的過程
- 2024-09-11國內(nèi)比較好的干細(xì)胞醫(yī)院排名榜最新
- 2024-08-04臍帶間質(zhì)干細(xì)胞存儲,臍帶間質(zhì)干細(xì)胞存儲方法
- 2024-10-11江蘇干細(xì)胞培養(yǎng)費用如何?價格與效果成正比嗎?
- 2024-08-27造血干細(xì)胞捐獻(xiàn)危害,對身體有影響
